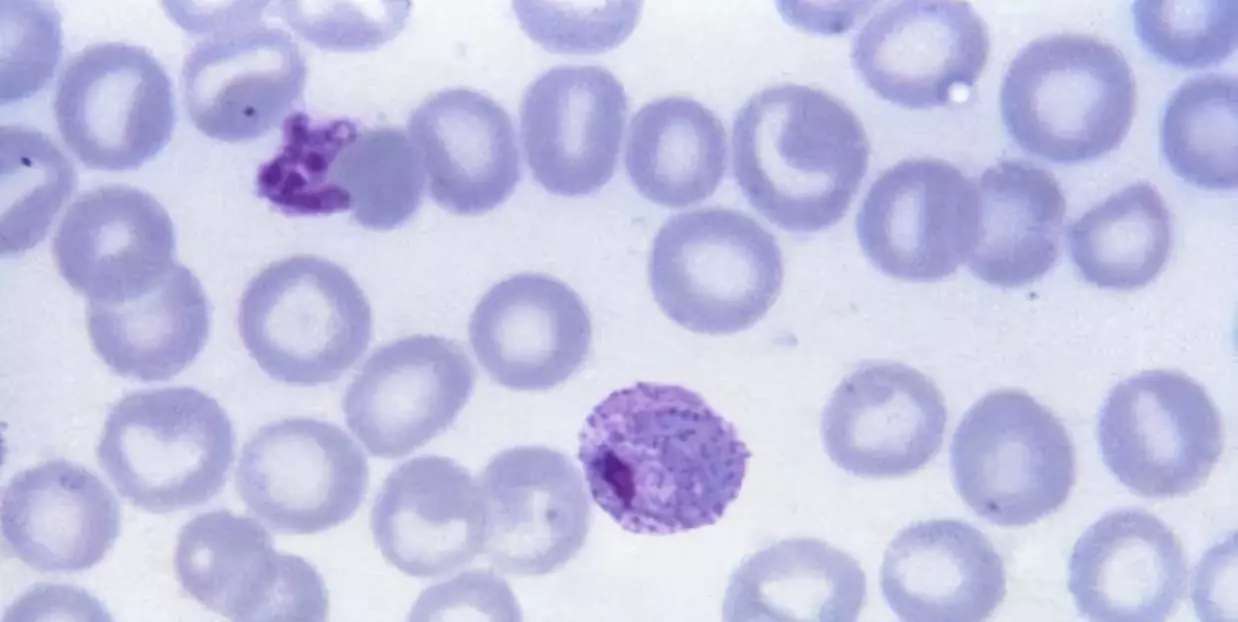
图片

用疟原虫治愈晚期癌症,靠谱么?
用疟原虫治愈晚期癌症,靠谱么?
文|菠萝
(一)
今年春节期间,和癌症相关的最大热点无疑是“疟原虫治愈癌症”,网-上传疯了,据说临床试验咨询电-话都打爆了!对于癌症患者和家属而言,“治愈晚期癌症”这个标题挑动了太多人的神经,唤起了巨大的希望。
到底是怎么回事儿?用疟疾以毒攻毒,真的能治愈晚期癌症么?
先摆明我的观点:
1:科学是开放的。“疟原虫治愈癌症”是个科学猜想,值得研究,逻辑很类似一百多年前的“科利毒素”。
2:这还是早期研究。目前参与人数还太少,也没有正式的临床研究论文,所以疗效和副作用都属于未知。
3:在临床数据发表之前,自媒体向大众宣传“疟原虫是抗癌神器”是不合适的,用“治愈”这个词更是严重误导。
4:对新诊断患者,不应该做为治疗的首选方案。对于标准治疗已经失败的患者,可以作为选择之一去了解,但需要降低预期。
(二)
“疟原虫治疗肿瘤”其实不是新闻,早在2017年,我已经看到相关报道。但2019年春节这个研究才突然被自媒体点燃,引发社会关注。
对大众而言,这种以毒攻毒的想法很疯狂,但如果是对肿瘤免疫治疗历史熟悉的人,应该不会感到特别意外。因为100多年前,就有人做了类似的事情。
他就是威廉·科利(William Coley),19世纪末美国的一名外科医生,现在被很多人称为“癌症免疫学之父”。
科利当时查找文献,发现有些肿瘤患者意外被细菌感染,严重高烧后,癌细胞居然自动消失了!这给了科利灵感:“难道细菌感染能“以毒攻毒”干掉癌细胞么?如果故意让患者被细菌感染,引起高烧,可能治好癌症!”
当时人类甚至还不知道免疫系统的存在,但也没有FDA这样的监管部门,所以科利说干就干,直接把致病活细菌,直接注射给癌症患者! 这就是所谓的“科利毒素”。
注射科利毒素后,很多患者都高烧不退,由于当年还没有抗生素,所以完全无法控制感染。很多人就这样直接发烧死了,但熬过来的一些人里面,确实有一些患者肿瘤消失了!

这被认为是第一批现代肿瘤免疫治疗试验,科利现在也被喻为“癌症免疫学之父”。
(这个故事菠萝详细写过:一位“民科”,如何逆袭成了癌症免疫治疗之父?<上篇> <下篇>)
大家仔细读科利毒素的故事就会发现,虽然当时用的是细菌,而现在中国科学家用的是寄生虫,但用“疟原虫治疗肿瘤”和100多年前用致病细菌治疗肿瘤是有很多相通之处的。
它们的本质,都是希望用一种外源病原体来刺激人体免疫系统,从而达到杀灭肿瘤细胞的效果。
我们究竟应该如何看待“疟原虫治疗肿瘤”?其实并不难,大家可以从历史长河中寻找答案,从科利毒素的故事获得感悟。
了解科利毒素的历史后,相信多数人会同意我的观点:疟原虫治疗肿瘤是值得深入研究的科学问题,但它还远不是救命稻草,我们需要非常谨慎。在有临床统计数据之前,不应该大规模宣传推广。
(三)
为什么说它是个有趣的尝试,值得科学家关注?
因为最近PD-1抗体等免疫新药的成功,证明了适当地激活免疫系统,确实可能控制晚期肿瘤。加上“科利毒素”当年确实治好了一些患者,我个人相信有人会因为感染刺激免疫系统后,意外清除癌细胞。细菌也好,病毒也好,寄生虫也好,确实有可能产生这种效果。
既然有希望,那为什么我们又要谨慎看待这个研究,在统计结果出现之前不应该过度宣传?
因为有许多核心的科学问题还没有被回答。
科利毕生都在研究和使用威廉毒素,据说他自己就治疗了近1000人,但“科利毒素”发明100多年来,从来没被推广,也没有成为主流疗法,最重要的原因,就是科利和后续研究者没有回答一些最重要的科学问题,包括:
1:它的严重副作用比例是多少?是否能控制?
2:客观有效率到底是多少?是否有大规模临床试验证明?
3:能否预测什么患者使用“科利毒素”会有效?什么患者无效?
4: 不相关的细菌感染,是如何激活人体免疫系统来清除肿瘤的?
“疟原虫治疗肿瘤”要想成功,也至少得回答这些问题。从目前公布的资料来看,
第1个问题,反复感染疟疾的副反应是不小的。虽然青蒿素短期可以控制感染和发热,但不清楚控制发热后,抗癌效果是否也会打折扣;
第2个问题,参与试验人数太少,还没有答案。10位随机患者无法形成有效结论;
第3个问题没有答案,但目前来看,单独使用疟原虫抗癌有效率并不高;
第4个问题有一些动物模型研究,但还没有人体数据。
由于这些有待回答的问题,这个临床试验还属于早期。网上也可以查到他们3个“疟原虫治疗肿瘤”的相关临床试验,都在1期或2期:
clinicaltrials.gov/ct2/show/NCT02786589
clinicaltrials.gov/ct2/show/NCT03474822
clinicaltrials.gov/ct2/show/NCT03375983
严格意义上来讲,直到临床研究论文发表,所有数据公开,那“疟原虫治疗肿瘤”试验的安全性和有效性都是未知的。
这样早期的临床试验,应该通过各种渠道招募没有选择的晚期患者参与,但通常并不适合通过大众媒体传播。
大众媒体的不准确宣传很容易造成误解,给患者带来不合理的预期,也给试验带来不可知的变数。
(四)
“疟原虫治疗肿瘤”能否真正成功,实现最大价值,取决于机理是否能搞清楚。也就是要回答,疟原虫到底是如何刺激免疫系统对抗癌细胞的?
无论站在流行病学角度,操作方便角度,还是剂量控制角度,我都很难想象大规模使用活的疟原虫来治疗肿瘤。即使有青蒿素控制疟原虫,但反复感染疟疾给身体带来的副作用,以及大量使用青蒿素带来耐药变异株也是显著的风险。
理论上而言,疟原虫感染人体如果真的导致肿瘤消失,最可能的机理有两类:
1:疟原虫感染激活了非特异的天然免疫(InnateImmunity)通路,从而顺便杀伤癌细胞。
2:疟原虫感染激活了特异的获得性免疫(AdaptiveImmunity)通路,本来是专门抗疟原虫,但由于免疫系统的复杂性,也意外能对抗某些癌细胞。
当然,或许两者皆有。
不管是哪一种原因,搞明白机理后,就可能找到一种不需要疟原虫感染,而直接激活对应的免疫因子的办法,从而以更安全有效的办法来对抗癌症。
在我看来,这才是最终的圣杯。
(五)
我非常理解,大家都很关心“疟原虫治疗肿瘤”这条新闻的原因。
站在科学角度,用寄生虫来治疗肿瘤确实鲜有人尝试,所以大家都充满了好奇。而屠呦呦和青蒿素的故事,让疟疾本身打上了厚重的“中国标签”,这个试验难免又添加了些感情因素。再加上“治愈晚期癌症”这样的标题党,让很多人燃起了希望。
但对临床科研而言,媒体的过早大范围曝光永远是一把双刃剑。
一方面,海量晚期癌症患者知道了这个消息,找到患者入组会更容易,试验进度估计会大大提前。
另一方面,国内外科学家都会关注这个试验,如果试验设计出现纰漏,或者进展不顺利,可能会引起很大舆论压力。
所谓“名气越大,责任越大”。
国内目前做事情普遍心急,科研圈也不例外,我们不缺聪明人,不缺好想法,但缺愿意耐心做事的人,缺能做出国际水准临床研究的团队。
衷心希望“疟原虫治疗肿瘤”的研究团队能沉住气,严格遵守按照科学方法,做出让人信服的数据。
实话实说,试验是成功还是失败并不重要。科学试验都有风险,何况是早期抗癌试验。只要试验设计和执行科学合理,即使失败的结果也将带来科学的进步,研究者都应该受到尊重。
无论科学家还是媒体人,我们永远都要记住:广大患者真正需要的,是扎实的科学进步,而不是昙花一现的新-闻。
就在我写完这篇文章的同时,意外收到了中科院研究团队成员给我的信-息。看来,夸大宣-传的受害者不止是患者和家属。

自-媒-体时代,获得信-息越来越容易,获得真相却越来越难了。
收藏
回复(5)参与评论
评论列表
 开心快乐291
开心快乐291























